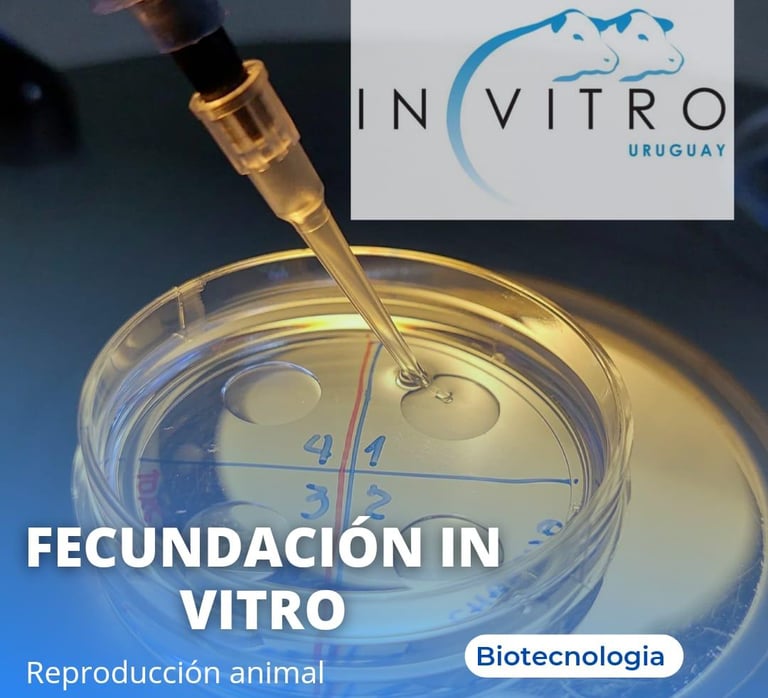
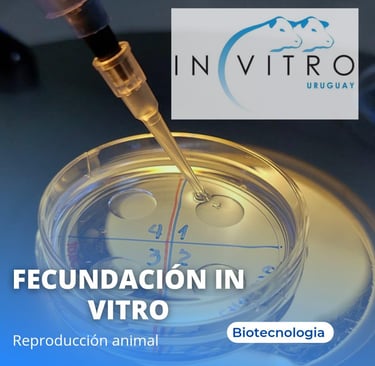
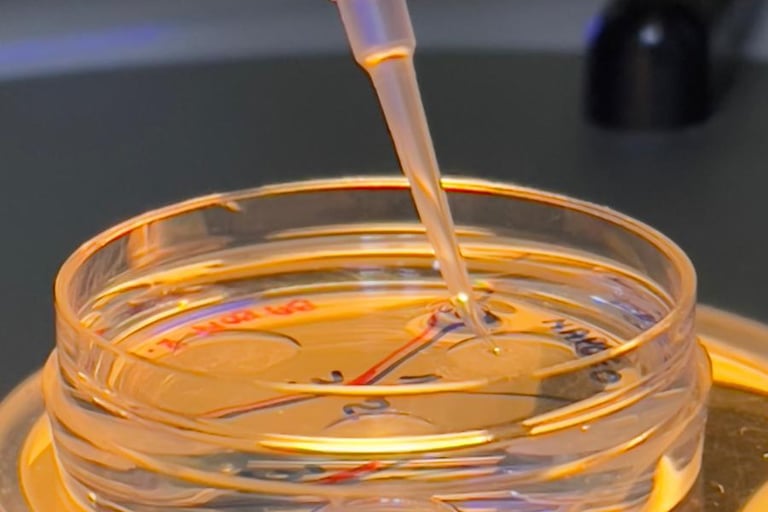
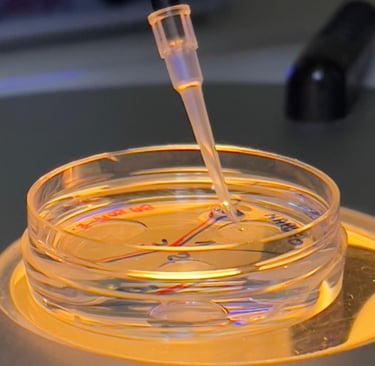

Bien-venidos à 3R Ganaderia
Embriones Braford y Brangus 3R: genética de excelencia, rusticidad y resultados.


Ganadería 3R nació con un propósito claro: transformar la tradición en innovación y ofrecer al mercado ganadero animales que reúnan rusticidad, eficiencia y calidad genética.
Nos dedicamos con seriedad a la investigación, al mejoramiento genético y al cuidado minucioso de cada detalle de nuestro plantel. El resultado es una línea de ejemplares que expresan el equilibrio perfecto entre fuerza, adaptación y productividad.
Estamos convencidos de que la ganadería moderna debe ser sustentable, rentable y, sobre todo, eficiente. Por eso seleccionamos con rigor a los mejores animales, priorizando características como fertilidad, resistencia, ganancia de peso y calidad de carcasa. Esta búsqueda constante nos ha convertido en una referencia en el desarrollo de animales adaptados a las condiciones más desafiantes del campo.
En 3R, cada logro es fruto del trabajo, la pasión y el compromiso con el futuro de la ganadería. Nuestro ganado lleva la marca de la rusticidad, pero también de la excelencia.
3R : Tradición, ciencia y potencia genética al servicio de un futuro más productivo.



Servicios 3R
Genética Braford y Brangus con respaldo técnico y confianza en cada paso.




Nuestros Productos
En Ganadería 3R ofrecemos embriones de las razas Braford y Brangus, desarrollados a partir de una rigurosa selección genética que garantiza rusticidad, eficiencia y alto potencial productivo.
Cada embrión es el resultado del trabajo en mejoramiento, pensado para quienes buscan animales adaptados, fértiles y de gran desempeño en diferentes condiciones de campo.
Con 3R, invertir en genética es asegurar un futuro más rentable y sustentable.

Nuestro Respaldo Técnico.
Para embriones de las razas: Brangus y Braford
O R I G E N
Una empresa de vanguardia técnica en reproducción animal y al servicio de la ganadería nacional.
Empresa uruguaya dedicada a la reproduccion bovina.
Especializada en la fertilización in vitro








Lopez Carlos
Consejero de 3R
Técnico de la Asociación Rural del Uruguay
Responsable de la clasificación de animales en Uruguay
Especialista en inspección, selección y registro de ganado de calidad


Nicolas Tourn Sosa
Médico Veterinario
Número Mgap 6022
UDELAR
REPÚBLICA ORIENTAL DEL URUGUAY


Tulio Luzardo
Consejero de 3R
Técnico responsable de la raza Braford en Brasil
Referente en evaluación genética, selección y mejoramiento de ganado de alta calidad
En Ganadería 3R contamos con el respaldo de un equipo técnico altamente especializado que nos acompaña en cada etapa del proceso productivo. Veterinarios, genetistas y asesores en reproducción garantizan calidad, eficiencia y resultados superiores en cada servicio y producto que ofrecemos.

Nueva alianza estratégica de Tres R.
Nos enorgullece anunciar la incorporación de In Vitro, el laboratorio responsable por el desarrollo de la raza Boran en Uruguay, reconocido por su tecnología avanzada y excelencia en biotecnología reproductiva.
Con más de 15 años de trayectoria, In Vitro Uruguay se ha consolidado como la empresa de mayor producción de embriones en la historia del país, superando los 140.000 embriones producidos, un marco que refleja su capacidad, innovación y liderazgo en el sector.
Esta alianza fortalece el compromiso de Tres R con la genética de alto nivel, la precisión técnica y la evolución constante de la ganadería, integrando conocimiento, experiencia y tecnología de vanguardia para ofrecer resultados superiores en cada generación

Galeria









Importamos genética Boran de excelencia.
Tecnología, trazabilidad y compromiso con el futuro de la ganadería Três R.

Suscríbete a Nuestro Boletín
Mantente al tanto de las novedades de la ganaderia!



